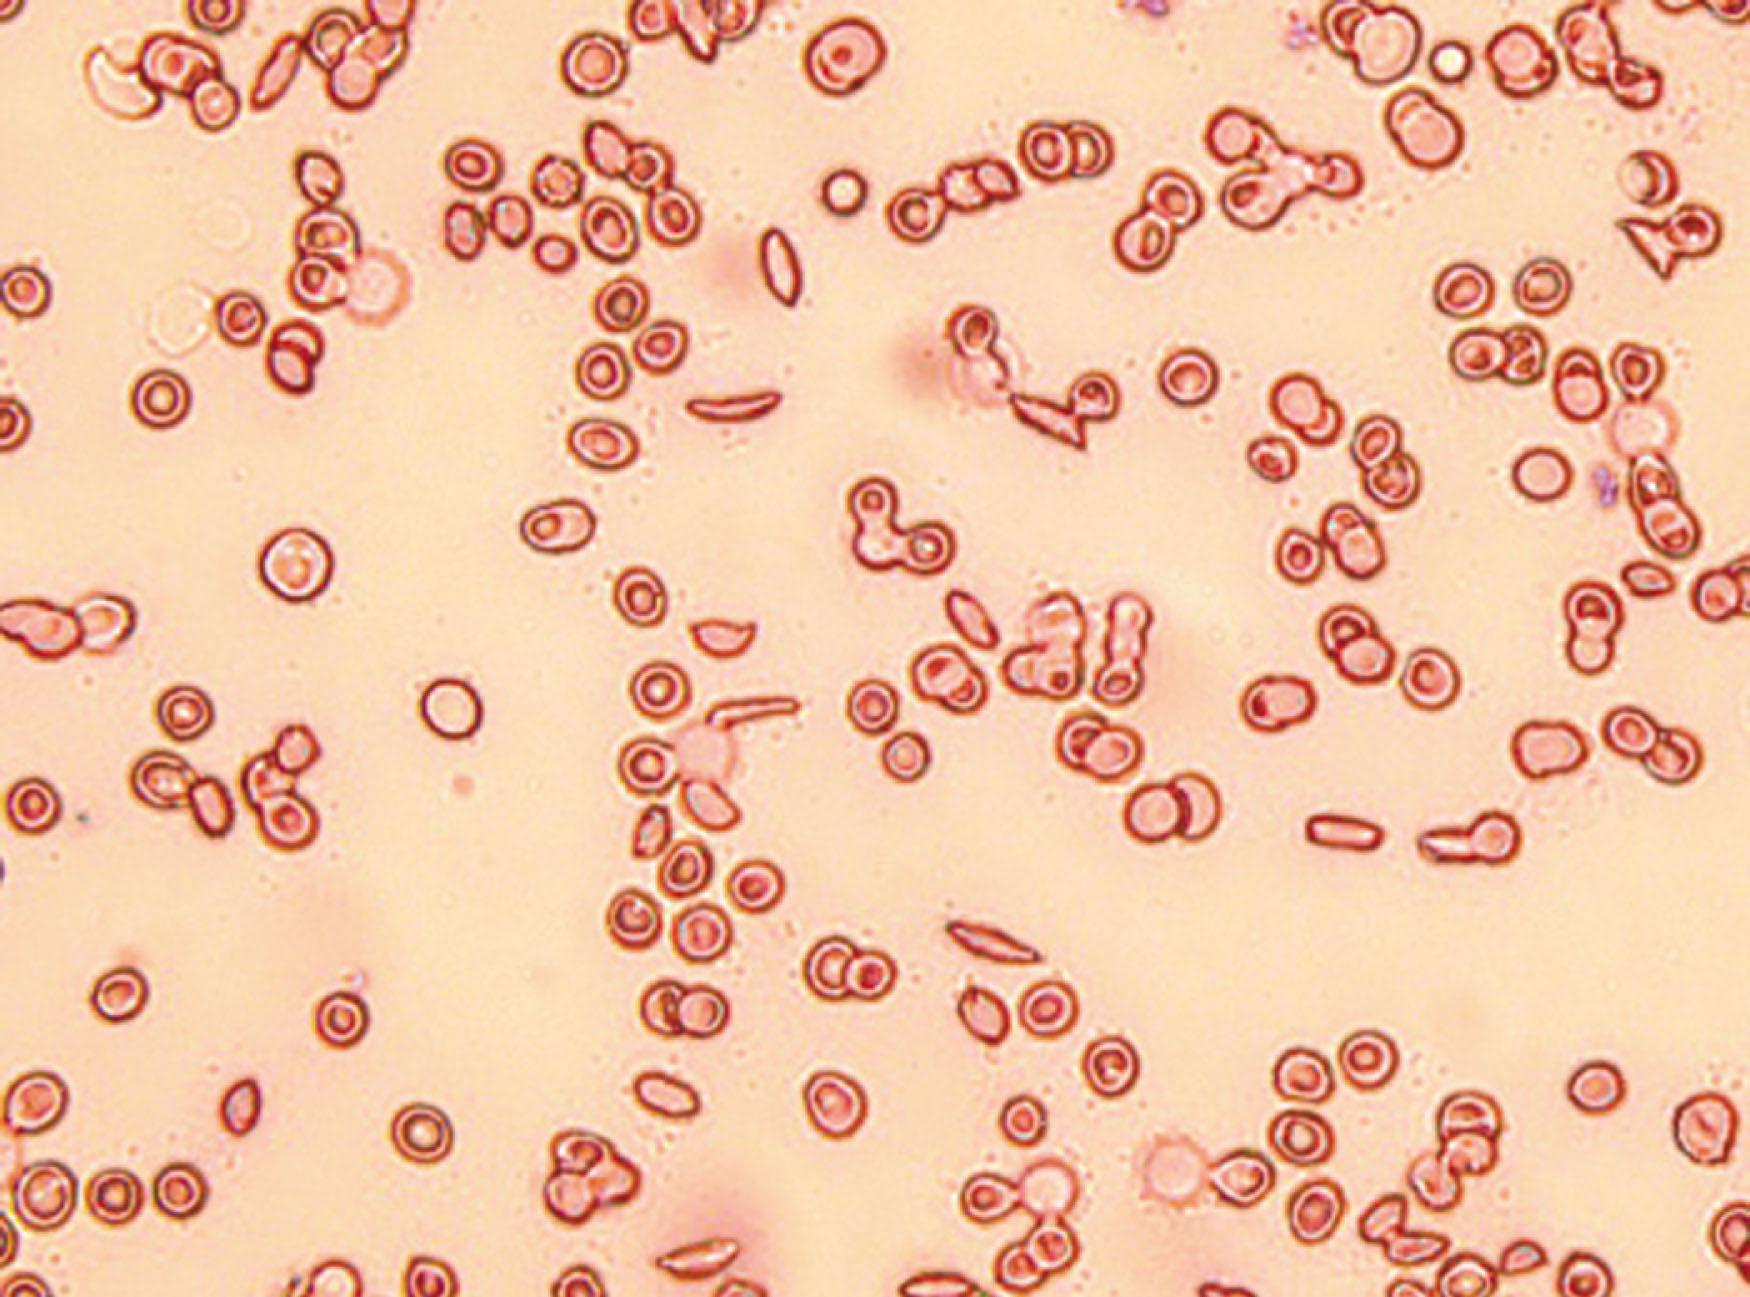
Figure 43.4, The peculiar elongated shapes of the erythrocytes is what Herrick's intern Ernest E. Irons noted, and together with a report from the German literature of sichel formen blood cells, inspired the name by which this condition is now known.

Physical Address
304 North Cardinal St.
Dorchester Center, MA 02124
Hemoglobinopathies are the most common genetic diseases in humans. In sickle cell disease (SCD), a single nucleotide substitution (GTG for GAG, rs334 ) in the sixth codon of the β-globin gene produces an abnormal sickle hemoglobin (HbS). Due to a change in the convention for numbering amino acid residues in the human β-hemoglobin chain, the HbS mutation becomes E7V rather than E6V and the current numbering puts the HbS mutation in codon 7 rather than 6. In addition to homozygosity for the HbS allele (HbSS), the phenotype of SCD encompasses other genotypes including HbSC (compound heterozygosity of HbS with HbC), and HbSβ-thalassemia (HbSβ 0 or HbSβ + -thalassemia, depending on the type of the β-thalassemia mutation) and rarer genotypes of HbS with hereditary persistence of fetal Hb (S/HPHH), HbS/HbE syndrome, as well as compound heterozygosity of HbS with HbD Los Angeles, HbO Arab, G-Philadelphia, and others.
All of these SCD genotypes have in common at least 50% HbS, the level of which is a key determinant of the SCD severity. Hence, HbSS and HbSβ 0 thalassemia, which have the highest proportion of intracellular HbS fraction (80% to 96% of total Hb), commonly referred to as sickle cell anemia (SCA), generally have a more severe disease course compared to the other SCD genotypes but even within each genotypic and ethnic group, a spectrum of clinical variability exists. Key contributors to observed clinical variability include environmental factors (weather, nutritional status, and access to social and medical support) and genetic background. Co-inheritance of α-thalassemia and genetic determinants of persistent fetal hemoglobin (HbF) production are established major genetic modifiers of SCD.
The key mechanism underlying SCD is polymerization of HbS under deoxygenated conditions altering the shape and function of red blood cells (RBCs). These “sickled” red cells initiate a series of events and the clinical hallmarks of the disease that include chronic hemolytic anemia and recurrent vaso-occlusive (VOC) episodes causing pain, acute chest syndrome (ACS), hepatic or splenic sequestration, and priapism. The end result is chronic organ damage from both microvascular and macrovascular vaso-occlusion. Once a disease with a high childhood mortality, improved childhood survival in well-resourced countries has transformed SCD into a chronic degenerative disease in adults with increasing morbidity due to complications in multiple organs, all contributing to the reduction in life expectancy by 20 to 30 years compared to the general population.
This chapter presents the diagnosis and natural history of SCD and describes overall clinical management as well as specific management by organ complications. Clinical interventions are founded on an understanding of underlying pathophysiologic processes. The exigency of living with a painful, life-threatening chronic disease in an ethnically diverse society adds complexity to the psychosocial aspects of this illness. A comprehensive management approach directed at preventing pain crises, chronic organ damage, and early mortality while effectively managing acute complications is recommended. For a full discussion of the history and molecular pathology of this disease, refer to Chapter 42 . Normal Hb synthesis, structure, and function are described in Chapter 34, and the thalassemias are described in depth in Chapter 41 .
Heterozygotes for the sickle gene (sickle trait or HbAS) who are generally asymptomatic have a substantial survival advantage in malaria-endemic environments. HbAS individuals are not only protected from effects of severe Plasmodium falciparum malaria but also from consequences of malaria infection, including malnutrition and bacterial infections, a result of which is the very high population frequencies of 10% to 20% in historically malaria-endemic regions. However, with the increased premature death rate of patients with SCD, the sickle cell gene represents a balanced polymorphism. Early genetic studies based on β S haplotypes generated by restriction fragment length polymorphisms in the globin-gene cluster on chromosome 11, hypothesized that the β S mutation arose and amplified separately in at least four African locations between 2000 and 4000 years ago and once in the Middle East or India. Recent studies based on whole-genome sequence data and phased single nucleotide polymorphisms (SNPs), however, suggest that rs334 arose once approximately 7300 years ago in West Africa on HAP1 haplotype from which the other haplotypes were then derived. Another study based on sequencing of the β-globin gene ( HBB ) cluster supported a single origin of rs334 but estimated an earlier origin about 22,000 years ago.
The sickle cell syndromes that result from inheritance of the sickle cell gene in simple heterozygosity or in compound heterozygosity with other mutant β-globin genes are sickle cell trait, HbSC disease, and HbSβ-thalassemia. These and other less common compound heterozygosity syndromes are reviewed.
The distribution and frequency of the sickle cell gene in geographic regions of the world have been influenced by natural selection and gene transmission via trade routes including the slave trade. In recent years, further expansion of the distribution of the sickle cell allele resulted from globalization. Among African Americans, the prevalence of sickle cell trait is 8% to 10% among newborns, and in this population, the frequencies of the sickle cell (0.045), HbC (0.015), and β-thalassemia (0.004) genes 16 indicate that there are 4000 to 5000 pregnancies a year at risk for SCD.
Based on data from the Centers for Disease Control and Prevention, there are approximately 100,000 individuals in the United States (US) with SCD. Overall, it is estimated that approximately 1 out of every 365 African American and 1 out of every 16,300 Hispanic American births in the US are affected by SCD. Approximately 3 million people (majority of African descent) and 8% of Black or African American individuals in the United States are sickle carriers. It is worth noting that due to both the presence of the HbS mutation in the Mediterranean region and to population admixture, sickle cell disorders can occur in individuals of European origin who do not report African ancestry.
The burden of this disease in the US is dwarfed by that in the rest of the world, evidenced by an estimated 300 million sickle carriers (~5% of the world’s population) globally, with 5.5 million AS births annually. Globally, it is estimated that more than 300,000 children are born with SCA every year, and this burden is expected to increase to 400,000 by 2050 largely due to reductions in infant mortality ; more than 50% of the births occur in Nigeria, Democratic Republic of Congo, and India.
The chronic hemolytic anemia of SCD presents with mild to moderately low Hb and hematocrit (Hct) levels and a reticulocytosis of approximately 3% to 15%. Additional laboratory features of hemolysis include unconjugated hyperbilirubinemia with relative elevations of both indirect (unconjugated) and total bilirubin, elevated lactate dehydrogenase (LDH), and low to absent haptoglobin levels. During vaso-occlusive episodes (VOEs), hemolytic laboratory parameters may become more pronounced with significant elevations in bilirubin, LDH, and reticulocyte counts above steady-state levels in addition to worsening of anemia. Baseline compensatory reticulocytosis in the setting of chronic hemolysis accounts for high or high-normal mean corpuscular volume (MCV). If the age-adjusted MCV is not elevated, the possibility of sickle cell–β-thalassemia, coincident α-thalassemia, or iron deficiency must be considered in the diagnostic work up.
In the peripheral smear ( Fig. 43.1 ), there may be sickled RBC forms, target cells, polychromasia indicative of reticulocytosis, and Howell-Jolly bodies in the setting of functional hyposplenia or asplenia. RBCs are typically normochromic unless there is coexistent thalassemia or iron deficiency. Sickled forms (irreversibly sickled cells [ISCs]) occur in the peripheral smear only in SCD and not in sickle cell trait. In HbSS disease, ISCs predominate, and target cells may be few; in HbSC disease, target cells predominate, and ISCs are rare; in sickle cell–β-thalassemia, ISCs, target cells, and hypochromic microcytic discocytes are prominent.

White blood cell (WBC) counts are higher than normal in HbSS and HbSβ 0 -thalassemia disease, particularly in patients under age 10 years. Mean WBC counts tend not to be elevated in HbSC disease or HbSβ + -thalassemia. Mean platelet counts are elevated in SCA, particularly in patients younger than age 18 years, but are usually normal in those with HbSC disease and HbSβ + -thalassemia.
Solubility test results (e.g., Sickledex) are positive in both SCD and sickle cell trait. All patients require definitive diagnosis with Hb electrophoresis (which separates Hb species according to amino acid composition) ( Fig. 43.2 ) or high-performance liquid chromatography (HPLC). Cellulose acetate electrophoresis at a pH of 8.4 is a standard method of separating HbS from other variants. However, HbS, G, and D have the same electrophoretic mobility with this method. Using citrate agar electrophoresis at pH 6.2, HbS has a different mobility than HbD and HbG, which comigrate with HbA in this system.

Results from electrophoresis or thin-layer isoelectric focusing are similar in HbSS disease and HbSβ0-thalassemia: nearly all of the Hb consists of HbS. Although differences in the HbF (see Variant Sickle Cell Syndromes) and HbA 2 levels may be useful in distinguishing these syndromes, the presence of microcytosis of one parent without sickle cell trait is a more useful indicator of HbSβ0-thalassemia or HbS–β + -thalassemia. The diagnosis of HbSC disease is straightforward; nearly equal amounts of HbS and HbC are detected. HbSβ + -thalassemia and sickle cell trait both have substantial amounts of HbA and HbS; whereas sickle cell trait is associated with neither anemia nor microcytosis and has an HbA fraction more than 50%, sickle cell–β + -thalassemia is associated with anemia, microcytosis, and an HbA fraction less than HbS, ranging from 5% to 30%.
Coinheritance of alpha-thalassemia (silent carrier or trait) is difficult to ascertain from standard hematology and requires DNA sequencing of the alpha-globin gene which can be performed as a send out test to specialized laboratories.
The HbF level is usually slightly to moderately elevated although there is significant variability among patients. The amount of HbF present is a function of the number of reticulocytes that contain HbF, the extent of selective survival of HbF-containing reticulocytes that become mature HbF-containing erythrocytes (F cells), the amount of HbF per F cell, and co-inheritance of HbF genetic variants, including the β S -haplotypes. The Arab–Indian and Senegal haplotypes are associated with higher levels of HbF than the others. HbF is also influenced by SCD-directed therapies, specifically hydroxyurea (HU), which will be discussed later in this chapter.
The use of prophylactic penicillin and the provision of comprehensive medical care during the first 5 years of life have reduced the mortality rate from approximately 25% to less than 3%, thereby underlining the importance of early identification of infants with SCD. Based on its economy and superiority of detection, universal screening of all newborns is preferred over ethnically targeted approaches. This screening approach was endorsed by a consensus panel convened by the National Institutes of Health. Since 2008, SCD screening in newborns is mandated in all 50 states of the US and the District of Columbia. Blood samples for testing are obtained by heel stick and spotted onto filter paper for stable transport and subsequent HPLC. It should be noted that HPLC screening in very premature newborns can result in misdiagnosis given that the switch from fetal to adult Hb has not completed and the level of HbS may still be below the threshold for solubility testing and the results may not be valid.
As HbS increases and HbF declines in the first months of life ( Fig. 43.3 ), the clinical manifestations of SCD, including anemia, emerge. ISCs can be seen on the peripheral blood smear ( Fig. 43.4 ) of children with SCA at 3 months of age, and by 4 months of age, moderately severe hemolytic anemia is evident.

Tests used in newborn screening must be capable of distinguishing between HbF, S, A, and C. The Hb distribution pattern is described in descending order according to the quantities detected. Therefore, a newborn with SCA who has predominantly HbF with a small amount of HbS and no HbA is described as having an FS pattern. An FS pattern is obtained also in newborns who have HbSβ°-thalassemia, HbS–hereditary persistence of HbF (HPFH), and HbSD or HbSG (since HbD and HbG have the same electrophoretic mobility as HbS). A newborn with sickle cell trait will have HbF, HbA, and HbS (FAS pattern). The quantity of HbA is greater than that of HbS. If the quantity of HbS exceeds that of HbA, the presumptive diagnosis is HbS/β + -thalassemia (FSA pattern). It may not be possible to distinguish FAS and FSA patterns in newborns, so DNA-based testing or repeat Hb testing at age 3 to 6 months is recommended. Several alternative, point-of-care approaches are currently under development and a commercially available kit utilizing an antibody-based lateral-flow assay is marketed under the name of Sickle SCAN.
The clinical manifestations of SCD include chronic hemolytic anemia, recurrent VOEs, and chronic end organ damage, particularly of the spleen, bones, brain, kidneys, lungs, skin, and heart. It is important to recognize that chronic organ damage is insidious and all SCD patients have decreased survival, even those with infrequent pain episodes or with a seemingly mild disease phenotype. The pattern of disease manifestation varies among the major genotypes of HbSS, HbSC, and HbSβ-thalassemia but also within the same genotype. Some of this variability is the result of coinherited genetic variants, for example, α-thalassemia or HPFH (refer to the end of this chapter).
This section begins with a brief overview of the natural history of SCD and survival followed by a discussion of disease-modifying therapies and then a discussion of organ-specific complications and their respective management.
The manifestations of disease begin after the first few months of life as HbF levels decline and HbS levels increase. Certain complications predominate in particular age groups. Between the ages of 1 and 3 years, affected individuals develop splenomegaly and splenic sequestration ( Fig. 43.5 ), pneumonia, and meningitis from Streptococcus pneumoniae and other encapsulated organisms because of functional hyposplenism, and hand–foot syndrome (dactylitis); in early childhood, ACS, osteonecrosis, and stroke predominate; in mid childhood, pain crises, osteonecrosis, and ACS are again common presentations; between ages 12 and 20 years, patients may develop strokes, priapism, and recurrent pain episodes.

As patients with SCD age, chronic end organ damage begins to manifest thereby complicating their clinical management and disease course. By the ages of 20 to 30, patients with SCD may develop sickle cell nephropathy with albuminuria, sickle retinopathy, sickle related liver disease, disabling avascular necrosis of multiple joints, recalcitrant leg ulcerations, and chronic pain. Pain becomes the most common complication, frequently acute-on-chronic; chronic pain is usually multifactorial secondary to ongoing inflammation, central and peripheral neural sensitization, and avascular necrosis.
Verbal and motor neurologic deficits secondary to prior overt strokes and neurocognitive deficits are common in adult SCD cohorts. In addition, complications related to SCD treatment such as transfusional iron overload and alloimmunization occur although these may develop in much younger individuals depending on clinical course and transfusion history.
Beyond age 30, patients demonstrate progressive worsening of end organ complications and may also develop age-related medical conditions such as osteoarthritis and diabetes mellitus. Aging patients with SCD are at high risk for developing pulmonary complications including pulmonary hypertension (PH) related to the underlying pathophysiology of the disease and/or recurrent thromboembolic events, termed chronic thromboembolic pulmonary hypertension (CTEPH). PH affects 6% to 11% of SCD adults and is a leading cause of morbidity and early mortality. Other pulmonary complications include reductions in vital capacity from pulmonary fibrosis due to parenchymal damage, manifested as impaired exercise tolerance, worsening heart failure, and impaired pulmonary function with evidence of restrictive physiology. Sickle cell chronic lung disease is a term used for these pulmonary lung complications but should be discouraged as these pulmonary complications are not unique to SCD. Exercise intolerance can also arise from associated high output and left ventricular heart failure in the setting of chronic anemia.
Albuminuria and Stage I–II chronic kidney disease (CKD) may progress to late-stage renal disease and overt renal failure requiring hemodialysis (HD) in approximately 4% to 12% of patients with SCD. A multidisciplinary approach integrating the expertise of hematology, cardiology, pulmonology, and nephrology is necessary in the medically complicated aging patient with SCD.
Life expectancy for individuals with SCD is decreased as compared to the general population without SCD, although over the past 30 years this has dramatically improved for patients in Western countries with access to comprehensive medical care. In 1973, Diggs reported that the mean survival was 14.3 years of age. In 1994, Platt et al. reported that life expectancy was 42 years for men and 48 years for women with SCD ( Fig. 43.6 ). Early improvements in survival trends were most likely the result of improved general medical care, including prophylactic penicillin therapy and vaccination against S. pneumoniae .

In a cohort of 542 adult patients with SCD followed at tertiary care medical centers in the Southeastern United States from 2002, the observed median survival for patients with HbSS and HbSβ 0 genotypes was 58 years, and median survival for HbSC and HbSβ + genotypes was 66 years. In a 2016 study involving 712 patients followed at King’s College Hospital in London, the median survival for patients with HbSS and HbSβ 0 disease was 67 years. This improved survival was attributed to expert care delivered at a specialized hematology clinic, comprehensive multidisciplinary inpatient management, involvement of specialists, availability of RBC exchange, and an established program to facilitate the safe and effective transition from pediatric to adult care. It is important to note that disease-modifying agents, such as HU, can improve survival in SCD cohorts. Because of its overall safety profile and efficacy, guidelines from both the US and UK recommend HU as standard care treatment for all individuals with HbSS and HbS/HbSβ 0 -thalassemia regardless of clinical severity as prevention/reduction of sickle-related complications. HU was US Food and Drug Administration (FDA) approved for use in adults in 1998 and in children in 2017.
The ability to predict clinical course allows for more rational tailoring of therapy to individual patients (e.g., selection of patients for high-risk but effective options such as stem cell transplant). While some clear predictors have been identified, the challenge is to predict “severe disease” before end organ complications manifest as reflected by commonly used clinical, laboratory, and imaging markers. Higher baseline HbF levels and the coinheritance of an α-thalassemia trait have been identified as favorable disease modifiers in multiple studies ( Table 43.1 ). The severity of chronic anemia is of considerable predictive value. Patients with more severe anemia are more likely to develop infarctive and hemorrhagic stroke, to have glomerular dysfunction, and are more likely to give birth to low-birthweight babies. Conversely, they have fewer episodes of ACS and after age 20 years, a lower mortality rate. Progressive anemia from renal, endocrine deficiency or a decrease in bone marrow function from vaso-occlusion is associated with early death.
| Reference | αα/αα a | −α/αα | −α/−α |
|---|---|---|---|
| Embury et al. | 7.8 b ( n = 25) c | 9.7 ( n = 18) | 9.2 ( n = 4) |
| Higgs et al. | 7.8 ( n = 88) | 8.1 ( n = 44) | 8.8 ( n = 44) |
| Steinberg et al. | 8.0 ( n = 73) | 9.0 ( n = 39) | 9.5 ( n = 13) |
| Felice et al.; age 5 years | 8.6 ( n = 88) | 8.4 ( n = 52) | 8.3 ( n = 50) |
| Felice et al.; age 11 years | 7.9 ( n = 40) | 8.5 ( n = 34) | 9.6 ( n = 2) |
a The different α-globin genotypes indicate the presence of four (αα/αα), three (−α/αα), or two (−α/−α) α -globin genes.
An early study aimed at identifying risk factors for mortality in adults utilizing algorithmic modeling in a cohort of 964 individuals with SCD identified ACS, renal failure, baseline white blood count greater than 15,000/μL, and a HbF of 8.6% or less to be associated with early death.
Risk factors for death in two contemporary adult SCD cohorts treated at tertiary medical centers included high frequency of hospitalizations, presence of iron overload, elevated tricuspid regurgitant jet velocity (TRJV) on transthoracic echocardiography (>2.5 m/s), history of any cerebrovascular event, lower estimated GFR, and at least one pain episode in the preceding year. Laboratory findings including low hemoglobin, high baseline WBC count, low baseline HbF, elevated LDH, high C-reactive protein (CRP), and elevated NT-proBNP were also predictive of early mortality in these patient cohorts. A more recent approach utilized novel machine learning methods to select variables of importance without any pre-conceived assumptions leading to the selection of nine key parameters and a simple risk score that reflects the summation of cardio-pulmonary, renal, and liver end-organ damage. An online tool was created to calculate this individual risk score and predicted survival in SCD patients.
In genome-wide association studies (GWAS), millions of genetic variants, typically SNPs, are queried for possible association with clinical subphenotype in patients with SCD. GWAS have been employed in SCD to study the genetic associations of HbF, bilirubin, cholelithiasis, hemolysis, HbA2 level, tricuspid regurgitation velocity, stroke, and systemic blood pressure. The UGT1A1 gene promoter variant which underlies Gilbert syndrome is a genetic modifier of bilirubin levels and prevalence of gallstones in patients with SCD. Bilirubin levels increase with hemolysis, and the intensity of hemolytic anemia is a marker of severity in SCD. Another validated result in SCD populations as a result of GWAS is the association of an SNP in NPRL3 with hemolysis. A number of other genetic polymorphisms may be relevant to disease severity and phenotype. However, the number of validated markers is small and at a stage that cannot be used to guide decision-making.
The pillars of therapy are disease modification (prevention of crises, complications, chronic end organ damage, and early mortality) and compassionate, prompt, effective, and safe relief of acute crises, including pain episodes. Therefore, outpatient clinic management is mostly directed at initiating measures to prevent pain crises, prevent organ complications, and improve survival. This effort should include identification of existing organ complications and initiation of measures to prevent further deterioration. Outpatient management can thus be divided into baseline evaluations, basic treatment or disease modification, and additional treatment dictated by the organ complications that are identified. The suggested treatments are based on current understanding of SCD pathophysiology. As shown in Fig. 43.7 , some treatments address only one aspect of pathophysiology, but others may have a broader impact.

Baseline blood, urine, and other evaluations are directed at quantifying chronic hemolytic anemia and organ-specific complications ( Table 43.2 ). They also provide baseline parameters that can be followed to assess response to therapeutic interventions.
| Tests | |
|---|---|
| Blood tests | CBC with differential |
| Reticulocyte count | |
| Hemoglobin HPLC or electrophoresis | |
| LDH | |
| Renal function tests | |
| Liver function tests | |
| Mineral panel | |
| Serum iron, ferritin, TIBC | |
| Vitamin D level | |
| Hepatitis B sAg | |
| Hepatitis C antibody | |
| RBC alloantibody screen | |
| RBC typing | |
| D-dimer a | |
| C-reactive protein a | |
| Brain natriuretic peptide | |
| Urine and kidney tests | Urinalysis |
| Renal ultrasonography b | |
| Radiology | MRI or MRA brain (adults) c or transcranial Doppler ultrasonography starting at age 2 years (children) |
| Chest radiography d | |
| Hip or shoulder radiograph or MRI (or both) c | |
| Bone density in teenagers and adults | |
| Cardiology and pulmonary | Echocardiogram |
| Neurocognitive | Neurocognitive testing d |
a Consider following as surrogate markers after initiation of disease-modifying intervention.
b If hematuria with red blood cells in urine.
d If the patient has poor school performance, an abnormal memory, or abnormal MRI findings.
In pediatric patients with HbSS disease and HbSβ°-thalassemia, at least annual assessment of cerebral blood flow in the internal carotid artery and the middle or anterior cerebral artery using transcranial Doppler ultrasonography (TCD) is recommended. TCD screening is initiated at age 2; it is not recommended in patients greater than 16 years of age. This evaluation is a validated predictor of stroke risk. Primary prevention with chronic transfusion to maintain the maximum hemoglobin S level at less than 30% is effective in such patients. Children with evidence of cognitive or neurologic dysfunction (e.g., poor school performance, concerns expressed by family members) should be screened for silent infarcts using magnetic resonance imaging (MRI). In adults, MRI or magnetic resonance angiography (MRA) of the brain can be used instead of TCD to assess thrombotic or hemorrhagic stroke risk, especially in those with a history of prior stroke or seizure.
The recognition of cardiopulmonary complications as a cause of early mortality in SCD warrants evaluation for this condition with either echocardiogram or brain natriuretic peptide (BNP) levels. In adult asymptomatic patients, baseline transthoracic echocardiogram should be considered for screening. If PH is suspected based on clinical symptoms or echocardiogram findings including borderline or elevated TRJV in an adult, a referral to a pulmonologist with consideration of right-heart catheterization is recommended.
The 2019 American Society of Hematology (ASH) Guidelines for Sickle Cell Disease advise aggressive blood pressure management in patients with a history of pre-hypertension or hypertension. Early treatment of systemic hypertension is critical; mild elevations in blood pressure are associated with an increased risk of overt stroke and silent cerebral infarct in patients with SCD. The ASH 2019 Guidelines strongly recommended a blood pressure goal of less than 130/80 to prevent progression of renal damage which results in chronic insufficiency and in later stages, renal failure.
Urinalysis and metabolic panel to screen for albuminuria and CKD should be assessed at baseline and at least annually. The National Heart, Lung, and Blood Institute (NHLBI) 2014 expert panel report stated that screening for albuminuria should occur annually beginning at 10 years of age for patients with SCD. In select patients with albuminuria, the use of angiotensin-converting enzyme (ACE) inhibitors or angiotensin II receptor blockers (ARBs) may be considered although caution must be exercised during initiation of therapy, particularly in the setting of concomitant renal insufficiency. While prospective data is limited, there is increasing evidence that early initiation of ACE inhibitors or ARB therapy may prevent progression of albuminuria and medical renal disease in patients with SCD.
Retinal evaluation is begun at age 10 and continued on an annual basis. More frequent retinal evaluations and ophthalmologic interventions are necessary if proliferative sickle cell retinopathy is noted.
In chronically transfused patients, ferritin levels should be serially measured at least every 3 to 4 months and must be drawn in the steady state (i.e., in the absence of acute pain crisis or VOC).
Chelation therapy is typically started after two years of transfusion in chronically transfused individuals, or after approximately 120 mL of transfused RBCs per kilogram, and when the serum ferritin exceeds at least 1000 μg/L or the liver iron concentration (LIC) is greater than 7 mg/g dry weight. Quantification of tissue iron stores should be undertaken to determine optimal timing of iron chelation therapy. At specialized centers, both hepatic and cardiac iron burden can be quantified non-invasively with MRI; although liver biopsy to assess LIC remains an alternative it is less desirable method. Patients receiving iron chelation should have serial iron indices and ferritin levels performed regularly and chelation regimen adjusted as needed.
Sufficient evidence suggests that a number of treatments should be considered in all patients. These treatments have been demonstrated to decrease symptoms and complications, increase survival, or both ( Table 43.3 ) (disease modification). There are other treatments for which there are sufficient scientific grounds or clinical data to suggest a potential impact on disease natural history. However, there is presently insufficient clinical data to make firm recommendations (see Fig. 43.7 and Table 43.3 ). Although treatments such as vaccination and penicillin prophylaxis do not directly affect the sickling process or vasculopathy, they have had an impact on survival and therefore are included under the umbrella of disease-modifying therapies.
| Robust clinical data | Penicillin prophylaxis |
| Streptococcus pneumoniae vaccination | |
| Hydroxyurea | |
| Chronic exchange transfusion | |
| Iron chelation for chronic iron overload b | |
| Limited clinical data | Daily multivitamin without iron or Folate supplementation AND vitamin D replacement c |
| Haemophilus influenzae vaccination | |
| Influenza vaccination | |
| Erythropoietin | |
| Phlebotomy | |
| Experimental | HbF reactivation with decitabine, histone deacetylase inhibitors, or IMiDs |
| Erythropoietin for chronic relative reticulocytopenia | |
| Nutritional supplements and antioxidants (e.g., glutamine, zinc, multivitamins) | |
| N -acetylcysteine |
a See text for specific indications and limitations.
Therapeutic options are further discussed in the sections describing organ-specific complications.
Chronic hemolysis results in increased utilization of folic acid stores. Megaloblastic crises from folic acid deficiency have been reported. Pediatric patients with SCD have higher homocysteine levels than age-matched control African American patients. Folic acid, 1 mg/day orally, is administered as a standard of care. Vitamin B 12 deficiency can also be seen in patients with SCD. Folate replacement can mask and possibly exacerbate vitamin B 12 deficiency.
A growing body of research indicates that sickle cell patients have multiple mineral and vitamin deficiencies, including zinc, vitamin C, vitamin E, acetylcysteine, calcium, vitamin D, and vitamin A. Fifty percent of children with SCD have evidence of osteoporosis or osteopenia that is associated with inadequate calcium and vitamin D intake. Recently, zinc supplementation in a prospective trial documented significant improvement in linear growth and weight gain in children with SCD. Therefore daily supplementation with a multivitamin without iron may be of value, and in pediatric and adult individuals with vitamin D deficiency (which is often severe ), vitamin D replacement therapy is warranted.
Despite increased intestinal absorption of iron in SCD, the combination of nutritional deficiency and urinary iron losses results in iron deficiency in 20% of children with SCD. The diagnosis of iron deficiency may be obscured by the elevated serum iron levels associated with chronic hemolysis, necessitating the detection of a low serum ferritin level or an elevated serum transferrin level for the diagnosis. The treatment of iron deficiency in children must be balanced with the potential risk for transfusion iron overload in the setting of RBC transfusions. In contrast, there are also reports that suggest iron-restricted erythropoiesis may reduce the frequency of VOCs due to the reduction of intracellular hemoglobin S concentration but to date, there have been no clinical trials to test this hypothesis.
Children with SCD should be immunized against Neisseria meningitidis, S. pneumoniae, Haemophilus influenzae type B, seasonal influenza, and hepatitis B in addition to all other standard vaccinations. Vaccination decreases the incidence of invasive pneumococcal disease in children with SCD. In the United States, a 13-valent pneumococcal conjugate vaccine (PCV13) and a 23-valent pneumococcal polysaccharide vaccine (PPSV23) are available. All children with SCD should be immunized with both PCV13 and PPSV23 as per American Academy of Pediatrics (AAP) guidelines. In adults, the Pneumovax should be re-administered every 5 years.
Penicillin prophylaxis begins at 3 months. The dose from age 3 months to 3 years is 125 mg penicillin V orally twice daily, and at age 3 years this should be increased to 250 mg twice daily until age 5 years. After the age of 5 years, penicillin prophylaxis can be stopped unless the patient has been splenectomized or there is a previous history of pneumococcal sepsis. Randomized, double-blind, placebo-controlled studies of prophylactic penicillin beginning in infancy, including the prophylactic penicillin or placebo study (PROPS), have found that this therapy reduced the incidence of S. pneumoniae bacteremia by 84% in children younger than 3 years. A randomized, double-blind, placebo-controlled study, the PROPS II study, concluded that it is safe to stop prophylactic penicillin therapy at age 5 years in children who have not had prior severe pneumococcal infection or splenectomy and are receiving regular follow up care. However, the power of the study was restricted by the limited number of S. pneumoniae systemic infection events. The decision of whether to continue antibiotic prophylaxis after age 5 must be made on a case-by-case basis. In an analysis of a patient population receiving penicillin prophylaxis and the Pneumovax, the rate of severe S. pneumoniae infections was 2.4 per 100 patient-years. This was favorable compared with the historic pre-penicillin prophylaxis rate of 3.2 to 6.9 per 100 patient-years. These measures reduce risk but do not remove it. The risk of recurrent S. pneumoniae sepsis and death in patients who have had previous sepsis is significantly increased; all patients with a history of pneumococcal sepsis should remain on penicillin prophylaxis indefinitely and are not candidates for outpatient management of febrile episodes. Parents must be aggressively counseled to seek medical attention for all febrile events.
The level of HbF in erythrocytes plays a critical role in determining patient outcomes. Individuals who have SCD and HPFH have 70% HbS in their RBCs but are neither anemic nor symptomatic. The uniform distribution of HbF among their RBCs interferes with HbS polymerization, increases its solubility, and prevents RBC sickling. Even at lower levels of HbF seen in patients without HPFH, crisis rate and mortality are inversely proportional to HbF level.
HU is an inhibitor of ribonucleotide reductase and a cytotoxic agent that elevates HbF levels via unknown pathways. Long-term use of HU in non-randomized studies has been associated with increased survival in patients with HbSS disease.
A double-blind, placebo-controlled, intention-to-treat multicenter study of HU as treatment of pain crisis in SCD found that HU produced definite hematologic changes. HU was initiated at 15 mg/kg/day and escalated to 0.30 mg/kg/day as tolerated and to maintain an absolute neutrophil count no lower than 2000 × 10 9 L −1 . There were significant increases in the levels of Hb, HbF, F cells, F reticulocytes, packed cell volume (PCV), and MCV and declines in the mean level of leukocytes, polymorphonuclear leukocytes, reticulocytes, and dense sickle cells ( Table 43.4 ). The significant clinical changes were decreased rate of acute painful episodes, longer interval to first and second acute painful episodes, fewer episodes of ACS, and diminished numbers of PRBC units transfused ( Table 43.5 ). In follow-up analysis, higher pre- or post-treatment HbF levels were associated with a reduction in mortality rate although no significant changes were observed in the incidence of stroke, hepatic sequestration, or death in the initial study. No short-term toxicity caused by HU was observed. One child born to a patient taking HU and two born to partners of patients taking HU were normal at birth. Although follow-up analyses suggest the importance of HbF to better outcomes, it is possible that some HU-induced changes in sickle cell erythrocytes, such as increased water content and decreased HbS concentration, may be independent of HbF.
| Variable | Hydroxyurea | Placebo | P |
|---|---|---|---|
| Leukocytes (103 cells/μL) | 9.9 | 12.2 | .0001 |
| PMNs (103 cells/μL) | 4.9 | 6.4 | .0001 |
| Reticulocytes (103 cells/μL) | 231 | 300 | .0001 |
| Hemoglobin (g/dL) | 9.1 | 8.5 | .0009 |
| PCV (%) | 27.0 | 25.1 | .0007 |
| MCV (fl) | 103 | 93 | .0001 |
| HbF (%) | 8.6 | 4.7 | .0001 |
| F cells (%) | 48 | 35 | .0001 |
| Dense sickle cells (%) | 11 | 13 | .004 |
| Variable | Hydroxyurea | Placebo | P |
|---|---|---|---|
| Acute pain crisis rate | 2.5/year | 4.5/year | <.001 |
| Hospitalization rate for acute pain crisis | 1.0/year | 2.4/year | <.001 |
| Interval to first pain crisis | 3.0 months | 1.5 months | <.001 |
| Interval to second pain crisis | 8.8 months | 4.6 months | <.001 |
| Acute chest syndrome | 25 | 51 | <.001 |
| Subjects transfused | 48 | 73 | .001 |
| Blood units transfused | 336 | 586 | .004 |
In the original study, only patients with two or more pain crises per year requiring hospitalization were eligible. However, other at-risk patients should be considered for HU therapy. These include patients with evidence of chronic organ damage, patients with severe anemia (unless the reticulocyte count is <250,000 μL −1 , in which case consider erythropoietin [EPO] deficiency from renal damage or bone marrow suppression that may require alternative treatment), and patients with indications for chronic transfusion but who have alloantibodies. After obtaining the baseline evaluations per Table 43.2 , HU is usually started at 500 to 1000 mg/day with monitoring of the CBC every 4 to 8 weeks to ensure that neutropenia (absolute neutrophil count <2 × 10 9 L −1 ) is not produced. Lower doses may be required in patients with renal insufficiency and/or relative reticulocytopenia. The dose may be increased to a stable maximum HbF response or neutropenia, but the majority of patients receive between 500 and 2000 mg/day. Response is defined by clinical symptoms, by a persistent and significant (>0.5 g/dL) increase in total Hb or HbF, and a decrease in LDH. These improvements in symptomatology and hematologic indices may require at least 3 to 4 months of therapy but can be seen as soon as week 6 of treatment.
In studies of HU as a therapy for children with SCD, the drug was well tolerated and produced favorable hematologic changes similar to those seen in the adult population. In approximately 10% of the children treated, the increase in HbF was less than 2%. Baseline HbF levels, baseline total Hb levels, and compliance were associated with the final HbF level. Other studies in children have documented a decrease in the number of days of hospitalization and suggest a decreased incidence of vaso-occlusive crises (VOCs). The favorable changes in hematologic indices suggest that HU therapy might be an alternative to blood transfusions for the prevention of recurrent stroke in children with SCD. HU therapy appears to lower transcranial Doppler velocities in children with SCD. Studies in the United States and in Belgium support the potential role of HU in the prevention of cerebrovascular accidents (CVAs). HU was found to improve, but not correct, the abnormal cerebral oxygen saturation associated with SCD. A persistent concern pertaining to the use of HU in SCD is its putative leukemogenic effect. This concern derives from reports on HU treatment of myeloproliferative diseases, conditions associated with an inherent propensity for leukemic conversion. Although the use of HU combined with 32 P or alkylating agents is associated with increased leukemic conversion in patients with myeloproliferative disease, reports claiming a leukemogenic effect for HU alone in polycythemia vera either lacked control subjects or were not designed to assess this issue. In children with the nonmalignant underlying condition of erythrocytosis secondary to inoperable cyanotic congenital heart disease, no leukemic conversion was observed.
Alternatives to HU for pharmacologic induction of HbF that have been studied in clinical trials include the methyltransferase inhibitor 5-aza-2-deoxycytidine (decitabine) and histone deacetylase inhibitors. These classes of agents act on chromatin processes that regulate gene transcription.
The methyltransferase inhibitors 5-azacytidine and 5-aza-2′-deoxycytidine have produced the largest increases in HbF of any of the pharmacologic reactivators of HbF that have been tested. Responding patients included those who did not respond to HU, consistent with a different mechanism of action. Although improvements in a number of surrogate clinical endpoints have been demonstrated, larger studies to confirm safety and clinical effectiveness with chronic use are required. In the United States, 5-azacytidine and decitabine have been approved by the FDA for the treatment of myelodysplastic syndrome (MDS). Decitabine, an analogue of 5-azacytidine, is also a potent DNA methyltransferase inhibitor and has a more favorable safety profile but decitabine is rapidly deaminated and inactivated by cytosine deaminase, if taken orally. To overcome this limitation, a clinical study combining decitabine and tetrahydrouridine (THU), a cytosine deaminase inhibitor, as a therapeutic strategy for inducing HbF, is currently under evaluation for efficacy in a phase II study, following promising results in a phase I study. The efficacy of the class of agents known as histone deacetylase inhibitors in HbF reactivation has been reviewed and includes Panobinostat, a pan histone deacetylase inhibitor. Other classes of drugs being evaluated for potential HbF reactivation are the “imid” class of drugs (analogues of thalidomide such as pomalidomide) and inhibitors of lysine demethylase (LSD1/KDM1A).
Voxelotor was approved by the FDA in November 2019 for the treatment of SCD in patients aged 12 years and older. Voxelotor inhibits sickling by preferentially binding to the high-oxygen affinity, non-polymerizing R conformation of hemoglobin, thereby reducing the concentration of the polymerizing T conformation and stabilizing the oxygenated hemoglobin state. Although there is a modest increase in hemoglobin that is accompanied by decreased markers of hemolysis, suggestive of reduced sickling, to date, there is no evidence that it reduces frequency of pain crises, prevents organ damage, or prolongs survival. Approval was based on the surrogate endpoint of Hb increase of at least 1.0 g/dL or greater from baseline at Week 24 of treatment. There is concern that Hb molecules with the drug bound are in a conformation that delivers very little oxygen, i.e., drug-induced reduction of functional oxygen content (FOC), which is particularly detrimental in a disease characterized by decreased oxygen delivery. Hopefully, these concerns will be addressed in current multicenter phase III clinical studies in both adults and children.
It is important to note that voxelotor interferes with determination of Hb fractions as per HPLC and may make routine HbF monitoring in patients receiving concomitant HU challenging. As such, it is recommended that baseline HPLC be obtained in patients receiving HU prior to initiating voxelotor therapy.
Crizanlizumab-tmca was approved by the FDA in November 2019, and represents the first in its class approved for reducing the frequency of VOCs in adult and pediatric patients aged 16 years and older. Crizanlizumab is a humanized monoclonal antibody to P-selectin and its mechanism of action is to block the abnormal adhesion of activated erythrocytes, neutrophils, and platelets to the endothelium. A phase II, multicenter, randomized, placebo controlled double-blind study of crizanlizumab with or without HU (SUSTAIN study) (ClinicalTrials.gov Identifier: NCT01895361) demonstrated that patients on the treatment arm had a significantly lower rate of sickle-related pain crises compared to placebo with a lower incidence of adverse events.
The primary efficacy endpoint in the SUSTAIN trial was the annualized rate of VOC episodes, which was a composite endpoint comprised of pain crisis, ACS, hepatic sequestration, splenic sequestration, and priapism. Post hoc analyses showed that more patients were VOC event-free in the crizanlizumab arm than in the placebo arm, and that crizanlizumab also significantly increased time-to-first VOC compared to placebo. A phase 3 interventional, multicenter, randomized, double-blind clinical trial is ongoing to assess safety and efficacy of crizanlizumab with or without HU in patients with SCD and history of VOC (ClinicalTrials.gov Identifier: NCT03814716). Infusion-related reactions were observed in 2 (3%) patients treated with the 5 mg/kg dose level in the SUSTAIN trial. Crizanlizumab can induce pseudothrombocytopenia on automated platelet counts when ethylenediaminetetraacetic acid (EDTA) tubes are implemented.
L-glutamine (an amino acid) taken twice daily in powder form was FDA-approved for preventing acute VOC events in children aged 5 years and older and adults with SCD in July 2017.
In a phase III study, L-glutamine demonstrated a 25% reduction in the median number of pain crisis, 30% less hospitalizations, and reduced acute chest episodes in children and adults with SCD with or without HU over a 48-week period. Interpretation of the results is complicated by high dropout rates that were observed with approximately 36% in the L-glutamine arm and 24% in placebo arm discontinuing the study early. It should be noted that one of the exclusion criteria for the study was renal insufficiency, a concern for SCD patients, many of whom have renal impairment (see box on Role of Novel Therapeutic Agents in Sickle Cell Disease ).
In 2017, L-glutamine (Endari), and in 2019, voxelotor and crizanlizumab were approved by the US FDA for the treatment of SCD. Voxelotor increases Hb levels whereas Endari and crizanlizumab were demonstrated to reduce the frequency of VOC events, including pain crises, as compared to placebo. There are no consensus-based algorithms to guide hematologists on how these drugs should be implemented in the clinical setting. Notably, all three drugs can be used concomitantly with hydroxyurea therapy and the majority of patients in the pivotal trials had been stabilized on hydroxyurea therapy prior to enrollment. So, when do we initiate these new agents in the management of SCD?
HU is an efficacious anti-sickling agent and has an established safety profile and therapeutic benefits for greater 30 years. HU is now considered standard of care for all individuals with sickle cell anemia, regardless of severity of disease, in both adults and children. Thus, before considering these newer agents, a trial of hydroxyurea therapy should initially be considered and dosage titrated for maximal benefit. Consider adding second-line agents only when response to HU is minimal despite stabilization on maximum tolerated dose (MTD). Choice of second agents depends on an individual’s clinical phenotype and what we are trying to achieve—improving baseline Hb levels or reducing the frequency of acute pain episodes.
If the main aim is to improve oxygen-carrying capacity, i.e., hemoglobin, consider supplementing HU with an ESA but some patients may be resistant to a subcutaneous route of administration. Long-term follow-up from final analysis of 72-week voxelotor treatment data is not yet available. Voxelotor can be considered in combination with HU, and also in patients intolerant to hydroxyurea secondary to significant cytopenias or adverse effects. There is some concern, however, that Hb molecules bound with voxelotor are in a conformation that delivers very little oxygen, which can be especially detrimental in a disease characterized by decreased oxygen delivery. Hence, special consideration must be paid to patients with prior stroke and silent cerebral infarcts. It should also be noted that HbS-voxelotor complexes, while useful in monitoring voxelotor therapy, cause interference with determination of HbS and HbF fractions in routine HPLC laboratory techniques.
HU has a proven efficacy in reducing frequency of VOCs and also ACS events, but some patients continue to experience recurrent acute pain episodes while on a MTD of HU. In such patients, crizanlizumab or Endari can be considered in addition to hydroxyurea therapy. While no improvements in baseline hemoglobin or reductions in hemolytic parameters can be anticipated based on the mechanism of the drug, a secondary effect in reduction of VOCs will be stabilization of patient’s Hb as VOC events are often accompanied by a drop in Hb. Patients initiating crizanlizumab need to be closely monitored for infusion-related reactions during the initiation of drug. As L-glutamine is an amino acid, one should be cautious in its use among SCD patients in whom renal and hepatic dysfunction are not uncommon.
At this time, allogeneic hematopoietic stem cell transplantation (HSCT) from an HLA-matched sibling donor (MSD) remains the only curative option for SCD, and improvements in conditioning have made this approach feasible in both pediatric and adult populations. Between 1986 and 2013, 1000 SCD patients received HLA-identical MSD HSCTs; the outcomes were excellent with 93% overall survival. Eighty-seven percent of the patients received myeloablative chemotherapy and the rest (13%), mainly adults, received reduced intensity chemotherapy. It is important to note that patients 16 years or older had worse overall survival (81% vs. 95% P = 001) and a higher probability of graft-versus-host disease (GVHD)-free survival (77% vs. 86% P = 001). As patients can be cured of their SCD without complete replacement of their bone marrow, siblings with sickle cell trait are acceptable as donors as stable mixed hemopoietic chimerism after BMT can be achieved.
Although myeloablative conditioning has achieved high rates of overall and event-free survival, the conditioning is too toxic for adult patients with pre-existing organ dysfunction. Reversal of the sickle hematology without complete replacement of the patient’s bone marrow led to the development of less intense conditioning regimens expanding allogeneic transplantation in adult patients who otherwise would not be able to tolerate intense myeloablative conditioning. Donors can be HbAA or HbAS, and in order to reverse the sickle hematological genotype, myeloid donor chimerism must exceed 20%. Recent data reported at least 95% cure in 234 children and young adults (<30 years of age) with SCA who received HSCT from an MSD, with no increase in mortality compared to the disease itself and with a better quality of life. The data also demonstrated that myeloablative HSCT can be a safe option for patients less than 15 years old if an MSD is available unless there is a clear and strong recommendation not to undergo transplant.
However, in the US, less than 15% of patients with SCD have HLA-matched siblings as donors, but a promising alternative donor source is haplo-identical family members. Studies are now underway in several centers to find a balance of a conditioning regimen that provides adequate immunosuppression without rejection and minimal GVHD. Other sources of hematopoietic stem cells (HSCs) include related umbilical cord blood and matched unrelated donors, the latter source of HSCs as an approach is limited by the probability of finding suitable donors for African and African American populations as per the National Marrow Donor Program. HLA-haploidentical HSCT following reduced-intensity conditioning has been reported to show promising results with prolonged and stable engraftment, but rejection remains a major obstacle as also reported for umbilical cord blood as donor source.
The issue of the cost-effectiveness of bone marrow transplantation (BMT) gains perspective from the comparative costs in the United States of $150,000 to $200,000 for an uncomplicated BMT versus up to $112,000 annually for conventional medical care of a chronically transfused, iron-overloaded patient.
Transfusions in SCD improve the oxygen-carrying capacity of blood and concomitantly dilute circulating sickled erythrocytes to improve microvascular circulation; they also suppress endogenous production of RBCs containing HbS.
Blood transfusions as a therapeutic option are used in both the acute and chronic setting. Apart from chronic RBC transfusion for stroke prevention or treatment in children, its use in many other medical situations, such as prevention of recurrent acute pain, priapism, leg ulcers, renal dysfunction, and PH, remains pragmatic based on observations and clinical experience.
The two main approaches to transfusion in SCD are simple transfusion and exchange transfusion. These transfusions can be administered in an acute/episodic fashion or on a chronic basis. Therefore, transfusion therapy in SCD is of the following types: episodic simple, episodic partial exchange, or chronic partial exchange. Exchange transfusion can also be manual or automated. In both simple and exchange transfusion, the target Hb level is 10 to 11 g/dL (hematocrit, 30%). Transfusing to a higher Hb or hematocrit level is avoided because a hematocrit level greater than 30% is associated with hyperviscosity if there is a substantial proportion of HbS in the blood. The aim of chronic transfusion (simple or exchange) is to maintain a relatively low concentration of HbS. The HbS% target will vary according to indication, HbS% of less than 30% for primary or secondary stroke prevention but when prescribed for other indications (e.g., recalcitrant leg ulceration), a relatively higher concentration of HbS% less than 40% to 50% may suffice. In partial-exchange transfusion, a proportion of the patient's RBCs are removed before transfusion of normal donor RBCs; this can be done manually through phlebotomy followed by transfusion or concurrently using an automated device. In patients who need chronic transfusions, partial exchange is recommended because of the reduced iron burden of this approach. Partial exchange is also indicated if the baseline Hb level is more than 10 g/dL. Simple transfusion in this instance risks exacerbating the clinical condition through increased viscosity. For critical illness, exchange transfusion is also preferred. Although the target HbS level should be less than 30% in exchange transfusion, decreasing HbS levels to less than 50% may suffice depending on the severity of the complication being treated.
The volumes required for simple and exchange transfusions ( Table 43.6 ) are particularly important for transfusing children. For normal-size adults, the general rule is that each unit of RBCs infused should approximately increase the Hb level by 1 g/dL.
| Dilutional effects of transfusion on HbS: PRBC volume (PRBCV) (mL) = (Hct d − Hct i ) × TBV × Hct rp B |
| Manual partial-exchange transfusion: a HbSf = 1 − (PRBCV × Hct rp )(TBV × Hct i ) + (PRBCV × Hct rp ) × HbS i C |
| Automated exchange transfusion: Exchange volume (mL) = (Hct d − Hct i ) × TBVHct rp − (Hct i + Hct d )2D |
| RBC volume (mL) = Hct i × TBV |
a In these formulas, Hct and HbS are fractions (e.g., 40% = 0.4).
Episodic simple transfusion should be considered for blood volume replacement in aplastic crisis and splenic sequestration crises and for protection when there is a more than 20% decrease in Hb from baseline from severe illness such as septicemia, severe VOCs, or Hb levels of less than 5 g/dL. Episodic simple or exchange transfusion should be considered for ACS, multi-organ failure, priapism, and preoperatively. The choice of simple versus exchange transfusion is determined by the pre-transfusion total Hb level and the severity of the illness.
In the preoperative setting, there is randomized data to support the use of preoperative transfusion to decrease the risk of complications, including ACS. Preoperative transfusions can be categorized as follows. (1) Top-up transfusions to a target Hb level of 10 g/dL. This is an appropriate intervention for patients with baseline Hb between 6.5 and 9 g/dL undergoing low- or medium-risk surgeries (e.g., cholecystectomy, joint replacement). (2) Partial exchange transfusion to achieve a target Hb level of 10 g/dL with an estimated HbS percentage of less than 60%. This is an appropriate intervention for patients with baseline Hb levels of greater than 9.5 g/dL undergoing low- or medium-risk surgeries as per above. (3) Exchange transfusion to achieve a target Hb level of 10 g/dL with an estimated HbS percentage of less than 30%. This procedure should be considered for patients with SCD undergoing high-risk surgeries (e.g., cardiothoracic surgery). In short, surgery, even low- or medium-risk surgery, is a substantial physiologic stressor for patients with SCD, even those who do not have high-risk characteristics at the time of surgery, and preoperative transfusion should be considered. A caveat is that extended phenotyping of transfused red cells should be performed, as discussed later in this chapter.
Chronic partial-exchange transfusion is indicated in primary and secondary prevention of cerebral thrombosis as discussed in the Neurologic Complications section.
Transfusion complications include alloimmunization, delayed hemolytic transfusion reactions (DHTR; discussed in Exacerbations of Anemia), iron overload, and transmission of blood-borne diseases, including hepatitis C. The incidence of alloimmunization in SCD is between 19% and 30% and usually occurs with fewer than 15 transfusions. Some patients seem to tolerate multiple transfusions without developing alloantibodies, but others are readily allosensitized. Alloimmunization to multiple RBC antigens often results in the development of autoantibodies which poses challenges in sourcing appropriately matched blood products. The high rate of alloimmunization in transfused sickle cell patients is partly attributable to minor blood group incompatibilities between the recipient and donor pool, which often differ in ethnicity. Ethnic mismatch of RBC antigens is not the only reason, however, as molecular analyses have revealed significant RH allelic diversity with mismatch between serological Rh phenotype and RHD or RHCE genotype in patients with SCD and African American blood donors. Due to the prevalence of RH genetic diversity in patients with SCD, matching of the donor and recipient RBC antigens at the molecular level may be the only way forward to avoid alloimmunization and a recent study has demonstrated that this is feasible. Antibodies against the C and E antigens of the Rh group, Kell (K) and Lewis, Duffy (Fya, Fyb), and Kidd (Jk) are common. In the Stroke Prevention Trial in Sickle Cell Anemia, the routine use of WBC-reduced RBCs matched for E, C, and Kell decreased the allosensitization rate compared with historical data from 3% to 0.5% per unit transfused and decreased the rate of hemolytic transfusion reactions by 90%. Therefore the recommended approach to preventing alloimmunization is to reduce leukocytes and perform extended phenotype matching for all patients (ABO, C, D, E, Kell, Kidd, Duffy, and S and s). Many blood transfusion centers in the US have also adopted molecular genotyping using microarray chips for RBC phenotype prediction. The management of a DHTR and transfusional iron overload are discussed under Exacerbations of Anemia later in this chapter.
Transmission of human immunodeficiency virus, hepatitis B and C, and human T-cell leukemia/lymphoma virus-1 has diminished with improved screening of banked units but remains an issue. In addition to better screening programs, the use of leukocyte-depleted RBC transfusions can reduce this hazard.
As mentioned, an Hb level of greater than 10 to 11 g/dL (hematocrit 30%) in the presence of substantial amounts of HbS (>30%) is associated with hyperviscosity. Symptoms of hyperviscosity are relatively non-specific and related to the affected vascular bed. Central nervous system hyperviscosity can be associated with central venous thrombosis or cerebral infarcts in patients with SCD. Some data indicate that phlebotomy to reduce the hematocrit and viscosity (and which may also address iron overload) can decrease the frequency of crises in HbSC or HbSβ+ disease. In HbSS disease, phlebotomy has successfully been used in combination with HU (which increases the Hb level) in secondary stroke prevention in patients previously treated with chronic transfusion. Phlebotomy alone has also been used in HbSS disease with baseline Hb levels of more than 9.5 g/dL with favorable results on the frequency and duration of pain crises. This benefit may have resulted from decreased hematocrit and viscosity and from a decrease in intracellular Hb concentration from iron deficiency. One approach to phlebotomy is to remove approximately 10 mL/kg of blood over 20 to 30 minutes followed by infusion of an equal volume of normal saline. This is repeated every 2 weeks until the target Hb level of 9 to 9.5 g/dL is achieved.
The chronic hemolytic anemia of SCD is partially compensated by vigorous reticulocytosis. A decrease in compensatory reticulocytosis will exacerbate already existent anemia and can be expected to increase clinical risk. Accordingly, chronic relative reticulocytopenia (defined as Hb <9 g/dL and absolute reticulocyte count <250,000 × 10 9 L −1 ) was identified as a significant risk factor for early mortality in a prospective cohort study of patients with SCD.
In the general population, evaluation of EPO levels is usually prompted by the combination of anemia and abnormal serum creatinine level. EPO levels are then interpreted in relationship to the Hb level to assess for the possibility of EPO deficiency. In patients with SCD, this approach to diagnosis has pitfalls. Patients with SCD are already anemic; therefore, gradual anemia exacerbation is easily missed, and clinicians must weigh many possible causes in the context of multisystem SCD pathology. Furthermore, patients with SCD have low serum creatinine levels at baseline and serum creatinine is a poor measure of renal function due to tubular secretion even when renal function is abnormal. Therefore, a substantial increase in serum creatinine from baseline may nonetheless remain below the threshold defined as abnormal for the general population, potentially disguising the presence of renal damage that is sufficient to decrease renal endocrine function. Furthermore, EPO levels are not readily interpretable and generally inappropriately low in the individual patient with SCD as the EPO-producing cells in the renal medulla are unable to properly sense hypoxia due to tubular dysfunction. One contributing factor could be increased uptake by the massive compensatory reticulocytosis. Further, EPO levels are lower in SCD adults than in children, and EPO levels are inappropriately lower in patients with chronic relative reticulocytopenia. Hence, EPO deficiency should be considered as a possible cause of progressive anemia in patients with absolute reticulocyte counts below 250,000 × 10 9 L −1 even if their serum creatinine levels are in the normal range. The cumulative published experience of EPO use in SCD is limited (52 patients). Although EPO by itself has been reported to increase HbF levels, the most important role for EPO may be as replacement therapy for EPO deficiency that causes relative reticulocytopenia and progressive anemia. EPO replacement can also facilitate enhanced HU dosing and HbF augmentation. In using recombinant human EPO, caution must be exercised not to elevate the hematocrit to levels that result in hyperviscosity. Also, the reticulocyte fraction is the most adhesive, and it is possible that EPO could exacerbate or trigger sickle cell crises. Patients with SCD may be relatively resistant to EPO and require doses higher than those used in other patients with chronic renal failure. The reasons for EPO resistance are unclear but may include increased inflammation-mediated suppression of erythropoiesis which could explain favorable responses in some patients when initiation of EPO is accompanied by a dose of IV iron despite adequate iron stores as demonstrated by ferritin levels.
EPO therapy is probably not indicated in patients receiving chronic transfusion therapy in whom encouraging endogenous HbS containing erythropoiesis may be counterproductive.
Early death is well described in association with iron overload in patients with β-thalassemia and hereditary hemochromatosis. Similarly, iron overload is a problem in chronically transfused patients with SCD, although the clinical significance depends on the degree and duration of overload. Excess iron is a cause of significant morbidity and mortality in patients with SCD and one mechanism relates to hepatic fibrosis and hemosiderosis-related cirrhosis of the liver. While individuals with SCD accumulate cardiac iron at a lower rate than thalassemia cohorts, they still remain at risk for cardiac hemosiderosis and cardiac iron deposition cannot be predicted by LIC. Cardiac iron monitoring utilizing non-invasive T2* MRI of the heart should be considered in patients who have undergone 5 to 8 years of transfusion therapy, or earlier in patients with markedly elevated ferritin or LIC.
Chelation guidelines for patients with SCD are similar to those for other chronically transfused, iron-overloaded patients. Steady state serum ferritin values should be no greater than 1000 to 1500 ng/mL (1000 to 1500 mcg/L). Notably, the serum ferritin level is not a good indicator of clinically significant iron overload. When cardiac iron overload is present, an aggressive chelation regimen is warranted, given the potential risk for fatal cardiac arrythmias.
Iron chelation options in the United States include deferoxamine (via continuous intravenous or subcutaneous infusion), deferasirox (orally), and deferiprone. Optimal dosing of a chelating agent is determined by age, iron stores, frequency of transfusions, and the presence of organ dysfunction. There is some data to support greater effectiveness of the oral agents, in particular deferiprone, in cardiac iron unloading, and together with the oral route of administration and toxicity profile, deferasirox or deferiprone are favored over deferoxamine. The side effect profile of deferasirox includes gastrointestinal symptoms; reversible, dose-dependent increases in serum creatinine; and liver dysfunction. Deferiprone carries a rare but significant risk of agranulocytosis in addition to hepatoxicity.
Newer FDA-approved methods of quantitating iron burden by FerriScan of the liver can avoid the need for liver biopsies.
In addition to monitoring iron stores, formal audiograms should be performed prior to initiation of chelation therapy and annually thereafter. Hearing loss is most frequently reported with deferoxamine treatment, especially at higher doses. Annual evaluation by an ophthalmologist should be performed to screen for visual complications. Serum metabolic panel, urine protein, and creatinine should be monitored monthly in individuals on deferasirox, and every 3 months in those receiving deferoxamine. Liver function tests should also be closely monitored in patients on chelation therapy.
Although there is clear evidence of activation of the coagulation system in SCD, the role of thrombogenesis in VOCs remains unclear. Similarly, there have been no thorough evaluations of the role of antiplatelet or antithrombotic agents for the treatment of SCD. D-dimer levels (a degradation product of cross-linked fibrin) increase during acute VOCs.
Minidose heparin, 5000 to 7500 units every 12 hours, administered to four patients for 2 to 6 years reduced hospitalization and emergency department time by 75%, and pretreatment pain frequency recurred after heparin was discontinued. Larger clinical studies will be required to better understand the risks and benefits of heparin therapy for acute VOCs in SCD. Heparin has not been studied for acute arterial stroke in patients with SCD but has a role in SCD-associated dural venous sinus thrombosis. The management of stroke is fully discussed under Specific Complications and Their Management.
Acenocoumarol was administered in low doses that achieved a mean international normalized ratio (INR) of 1.64 and reduced the elevated levels of prothrombin activation fragment (fragment 1+2) to 50% of pretreatment levels. Clinical endpoints were not measured. In a crossover study, 29 patients were treated with acenocoumarol to target an INR of 1.6 to 2.0. No effect on crisis frequency was noted, although again, there were significant reductions in markers of coagulation system activation. In 37 acutely ill sickle cell patients with elevated D-dimers, the effect of low-dose warfarin therapy (1 mg without a target INR) in 12 patients was examined. In multivariate analysis, low-dose warfarin was the only variable associated with a significant decrease in D-dimer levels, suggesting a warfarin-induced decrease in thrombin activity. Therefore oral anticoagulation, even at low doses, is associated with a decrease in laboratory markers of coagulation pathway activation in SCD; however, further clinical trials are required to understand the clinical risks and benefits.
Platelet counts are often elevated and activated in patients with SCD. Anti-platelet agents as potential anti-sickling agents, however, have been disappointing. Aspirin was the first anti-platelet drug to be considered; one study compared aspirin with placebo in 49 pediatric patients with SCD in a double-blind crossover study. The frequency and severity of crises were not affected by aspirin therapy, and aspirin did not significantly affect Hb levels. Cerebral thrombosis, which accounts for 70% to 80% of all CVAs in SCD, results from large-vessel occlusion ( Fig. 43.8 ) rather than the more typical microvascular occlusion of SCD. In the United States, a clinical trial testing the safety and efficacy of aspirin in diminishing the incidence and progression of cognitive defects and overt or silent stroke in pediatric patients (START) was completed in 2009 but to date, the results of this study have not appeared in print. Antiplatelet therapy with clopidogrel in patients with SCD, unfortunately, was also disappointing. New, third-generation P2Y12 inhibitors such as ticagrelor and prasugrel have also been studied in patients with SCD. Although prasugrel showed appropriate levels of anti-platelet aggregation compared to healthy patients in ex vivo studies, and was well tolerated by patients, in a phase III (DOVE) study involving 341 children and adolescents, there was no significant difference in the rate of VOCs between the treatment group and placebo, and the study was terminated early. Ticagrelor, in a phase IIB study, was well tolerated, but failed to show effect in the frequency of VOC. While aspirin as an anticoagulant therapy did not provide benefit over placebo, it continues to be used as an analgesic in many parts of Africa.

The management of stroke risk and stroke is fully discussed under Specific Complications and Their Management.
Gene-based studies using different therapeutic strategies are currently ongoing, some in their early stages. Studies directed at the BCL11A gene for therapeutic reactivation of fetal hemoglobin show great promise and include two different experimental approaches: (1) addition of a lentiviral vector encoding a short hairpin RNA (shRNA) targeting erythroid-specific expression of BCL11A, thus encouraging endogenous HbF production ; (2) using CRISPR/Cas9-mediated gene editing to disrupt the erythroid-specific enhancer of the BCL11A gene. Precise correction of the sickle mutation converting the sickle allele to a normal β-globin allele is the most direct approach but the approach is still fraught with challenges.
Acute pain is the first symptom of disease in more than 25% of patients and is the most frequent symptom after age 2 years. Pain is the complication for which patients with SCD most commonly seek medical attention. An episode of acute pain was originally called a “sickle cell crisis” by Diggs, who used the expression “crisis” to refer to any new rapidly developing syndrome in the life of a patient with SCD. Pain crises result from vaso-occlusion of the bone marrow vasculature causing bone infarction, which in turn releases inflammatory mediators that activate afferent nociceptors.
Although a general correlation of vaso-occlusive severity and genotype has been posited, there is tremendous variability within genotypes and in the same patient over time. In one large study of patients with HbSS disease, one-third rarely had pain, one-third were hospitalized for pain approximately two to six times per year, and one-third had more than six pain-related hospitalizations per year. Over a 5-year period in the National Cooperative Study of SCD, 40% of patients had no painful episodes, and 5% of patients accounted for one-third of the emergency department visits. Pain is more frequent with the HbSS genotype, low levels of HbF, higher Hb levels, and sleep apnea. The frequency of pain peaks between ages 19 and 39 years. After the age of 19 years, more frequent pain correlates with a higher mortality rate. Medical personnel who see patients only in the emergency department gain a biased view of SCD skewed by a frequently affected minority with severe disease.
Pain may be precipitated by events such as cold weather and extreme heat which may induce rapid cooling of the skin via sweating, dehydration, infection, stress, menses, and alcohol consumption. Underlying etiologies should be searched for and corrected, but the majority of painful episodes have no identifiable cause. Pain can affect any area of the body, most commonly the back, chest, extremities, and abdomen; may vary from trivial to excruciating; and is usually endured at home without a visit to the emergency department. There may be premonitory symptoms. In adults, the average length of hospital admission is 7.5 days in contrast to only 4.4 days in children. Painful episodes are biopsychosocial events caused by vaso-occlusion in an area of the body having nociceptors and nerves. Pain is an effect and, as such, consists of sensory, perceptual, cognitive, and emotional components. Frequent pain generates feelings of despair, depression, and apathy that interfere with everyday life and promote an existence that revolves around pain. This scenario may lead to a chronic debilitating pain syndrome in some patients.
There is no specific clinical or laboratory finding pathognomonic of pain crisis. The diagnosis is established by history and physical examination. Changes in steady-state Hb values, hemolytic parameters, sickled cells on blood smear, and WBC counts are not reliable indicators. Numerous laboratory tests, leukocytosis, D-dimer, fragments of fibrin, and markers of platelet activation have been found to lack specificity as indicators of acute vaso-occlusion. Often patients can tell if they are having a typical pain crisis or something more sinister. It is thus good practice to ask the patient if symptoms are representative of their usual pain crisis.
Initial medical assessment should focus on detection of triggers or medical complications requiring specific therapy, which include viral or bacterial infection, dehydration, ACS (fever, tachypnea, chest pain, hypoxia, and chest signs), severe anemia, cholecystitis, splenic enlargement, neurologic events, and priapism. Pain management should be aggressive to make the pain tolerable and enable patients to attain maximum functional ability. To make the patient pain free is an unrealistic goal and risks oversedation and hypoventilation, which must be avoided. A pain chart should be started and analgesia titrated against the patient's reported pain together with medical assessment of the patient's overall clinical status. When clinicians consistently observe a disparity between patients' verbal self-report of their pain and their ability to function, further assessment should be performed to ascertain the reason for disparity. Patients are often undertreated for pain because many physicians and healthcare providers are overly concerned with the potential for addiction. Undertreatment of pain is no more desirable than overtreatment and oversedation; undertreatment can prolong the duration of a painful episode and can weaken the relationship between a patient and their healthcare providers. The benefit of early and aggressive treatment of pain was demonstrated in a study that incorporated rapid administration of intravenous morphine with the addition of long acting opioid therapies in 50 patients with SCD; overall, emergency department visits decreased and hospital admissions and length of stay dramatically declined in patients with the greatest frequency of acute pain episodes. Many centers have incorporated protocols and guidelines for rapid treatment of acute pain in day hospital settings which results in a striking reduction in emergency room visits and admission rates, as well as healthcare associated costs.
The pain pathway should be targeted at different points with different agents, avoiding toxicity with any one class ( Table 43.7 ). The mainstays are nonsteroidal anti-inflammatory drugs (NSAIDs), acetaminophen, and opioids. NSAIDs can be used to control mild to moderate pain and may have an additive role in combination with opioids for severe pain. The most potent NSAID is ketorolac. NSAIDs should be used with caution in those with a history of peptic ulcer disease, renal insufficiency, asthma, or bleeding tendencies. Within limits, use the agents that the patients know work for them and avoid meperidine (Demerol), which should only be used under very exceptional circumstances. Sedatives and anxiolytics alone should not be used to manage pain because they can mask the behavioral response to pain without providing analgesia.
| Dose/Rate | Comments | |
|---|---|---|
| Severe to Moderate Pain | ||
| Morphine |
|
Drug of choice for pain; lower doses in elderly adults and infants and in patients with liver failure or impaired ventilation |
| Meperidine |
|
Increased incidence of seizures; avoid in patients with renal or neurologic disease and those who receive MAOIs |
| Hydromorphone |
|
|
| Oxycodone | PO: 0.15 mg/kg/dose every 4 h | |
| Ketorolac | IM: Adults: 30 or 60 mg initial dose followed by 15–30 mg; children: 1 mg/kg load followed by 0.5 mg/kg every 6 h | Equal efficacy to 6 mg MS; helps narcotic-sparing effect; not to exceed 5 days; maximum, 150 mg first day, 120 mg maximum on subsequent days; may cause gastric irritation |
| Butorphanol | Parenteral: Adults: 2 mg every 3–4 h | Agonist–antagonist; can precipitate withdrawal if given to patients who are being treated with agonists |
| Mild Pain | ||
| Codeine |
|
Mild to moderate pain not relieved by aspirin or acetaminophen; can cause nausea and vomiting |
| Aspirin | PO: Adults: 0.3–6 mg every 4–6 h; children: 10 mg/kg every 4 h | Often given with a narcotic to enhance analgesia; can cause gastric irritation; avoid in febrile children |
| Acetaminophen | PO: Adults: 0.3–0.6 g every 4 h; children: 10 mg/kg | Often given with a narcotic to enhance analgesia |
| Ibuprofen | PO: Adults: 300–400 mg every 4 h; children: 5–10 mg/kg every 6–8 h | Can cause gastric irritation |
| Naproxen | PO: Adults: 500 mg/dose initially and then 250 every 8–12 h; children: 10 mg/kg/day (5 mg/kg every 12 h) | Long duration of action; can cause gastric irritation |
| Indomethacin | PO: Adults: 25 mg every 8 h; children: 1–3 mg/kg/day given 3 or 4 times | Contraindicated in psychiatric, neurologic, renal diseases; high incidence of gastric irritation; useful in gout |
Treatment of persistent or moderate to severe pain should be based on increasing the opioid strength or dose. In assessing patient responses to conventional doses of analgesia, it must be remembered that individuals with SCD metabolize narcotics rapidly. One approach is to administer morphine 0.1mg/kg SLT intravenously or subcutaneously every 20 minutes until pain is controlled. The patient should be checked at 20-minute intervals for pain; respiratory rate, depth, and quality; and sedation until the patient is stable with adequate pain control. Subsequently, the patient should receive a maintenance dose of 0.05 to 0.15 mg/kg SLT intravenously or subcutaneously every 2 to 4 hours. A rescue dose of 50% of the maintenance dose can be considered on an as-needed basis every 30 minutes for breakthrough pain.
During maintenance with opioids, pain control, respiratory rate, depth, and quality, and oxygen saturation should be monitored approximately every 2 hours. If respiratory depression is noted, omit the maintenance dose of morphine. For severe respiratory depression or oxygen desaturation, administer naloxone. Incentive spirometry and mandatory time out of bed are helpful in patients with chest pain to decrease the risk for hypoventilation. Severe or intractable pruritus is a common problem encountered in patients requiring high doses of opioids necessitating non-sedating antihistamine therapy or the addition of a 5-HT3 receptor antagonist. Laxatives or stool softeners should be prescribed to prevent opioid-induced constipation.
When intravenous dosing of opioids is roughly equivalent to home doses of oral medications, consider gradually tapering the dose by 10% to 20% at a time and subsequently switching from parenteral to oral administration of opioids once pain symptoms have stabilized. In general, opioids should be tapered by decreasing the dose rather than by increasing the interval between doses. For adult patients whose pain requires several or many days to resolve, a sustained-release opioid preparation is appropriate and provides more consistent analgesia.
Hydration is a critical part of management. However, cardiac function may be significantly impaired, especially in adult patients, and caution should be exercised with intravenous fluid management to avoid iatrogenic fluid overload. Patients with SCD cannot concentrate their urine and are at risk for dehydration when not taking adequate fluids (60 mL/kg/24 h in adults). Intravenous hydration is indicated when the patient is not taking oral fluids adequately. Ideally, the urine specific gravity should be kept under 1.010 daily. Hb may decrease by 1 to 2 g/dL in an uncomplicated pain crisis; blood transfusion is not routinely indicated for an uncomplicated pain crisis.
Equianalgesic doses of oral opioids should be prescribed for home use when necessary to maintain the relief achieved in the emergency department or hospital. Care should be taken to appropriately taper opioids in patients who have received daily opioids over many days. In these patients, there may be physical opiate dependence, which is characterized by the onset of acute withdrawal symptoms upon cessation of opioid administration. For patients at risk for physical dependence, opiates should be titrated downward by 15% to 20% per day. All patients with SCD should receive pain prescriptions from the hospital pharmacy prior to discharge; discharge without opioid medications is associated with higher 30-day readmission rates. A follow-up visit in the outpatient clinic should be scheduled within one to two weeks of discharge.
If the patient is not taking a disease-modifying agent such as HU, consideration should be given to initiating such therapy either as an inpatient or during follow up in the outpatient setting (see Case 1 ).
Chronic pain occurs in at least 29% of adults with SCD and is most frequently reported in those 25 to 44 years of age. The mechanisms of chronic pain in SCD remain poorly understood and are multifactorial secondary to a number of biopsychosocial variables. In the post-hematopoietic stem cell transplantation setting, a subgroup of patients with SCD have persistence of chronic pain despite reversal of the underlying disease process, suggesting that individual and environmental factors play a role in pain phenotype. Chronic pain can be challenging to treat and involvement of Palliative Care specialists early in the disease course is highly recommended.
Adequate analgesia with both short- and long-acting opiates is important to maintain the psychosocial functioning of patients who suffer from chronic pain. Underlying identifiable etiologies including avascular necrosis, early degenerative changes, or osteoarthritis should be addressed with orthopedic evaluation and potentially joint replacement in the case of femoral head necrosis. Agents including gabapentin, amitriptyline, and some antiseizure medications can address neuropathic components and decrease the sleep impairment that can occur with chronic pain. Given the high incidence of comorbid depression, all individuals should be screened for depressive symptoms and be considered for pharmacotherapy if major depressive disorder is diagnosed. Several antidepressants, including serotonin and norepinephrine reuptake inhibitors (SNRIs), are effective in the treatment of chronic pain and can be considered after consulting with mental health professionals and considering side effect profiles.
Chronic hemolytic anemia is one of the hallmarks of SCD. Sickle erythrocytes are destroyed randomly, with a mean life span of about 17 days. The overall hemolytic rate reflects the number of ISCs. The degree of anemia is most severe in SCA (HbSS), and HbSβ°-thalassemia, milder in HbSβ + -thalassemia and HbSC disease, and, among patients with SCA, less severe in those who have coexistent α-thalassemia ( Table 43.8 and see Table 43.1 ).
A 40-year-old African American female with sickle cell anemia complicated by frequent VOC, and sickle cell nephropathy, presented with acute pain and was subsequently hospitalized for IV analgesia and supportive care. Admission hemoglobin was 7.9 g/dL with elevated hemolytic parameters from baseline consistent with acute pain crisis. She was initiated on IV hydromorphone, parenteral NSAIDs for the first 24 hours, and subsequently transitioned to a hydromorphone PCA on Day 2 of hospitalization for improved pain control. She stabilized with conservative management but on Day 5 of hospitalization developed chest pain associated with mild dyspnea, non-productive cough, and low-grade fever.
Physical evaluation was notable for a new onset hypoxia (SpO 2 88% on room air), tachypnea, fever, and the patient was also mildly distressed. Apart from decreased breath sounds in the right lower lung base, the rest of the physical exam was unremarkable. The patient’s hypoxia resolved on 2 L nasal cannula and the patient was encouraged to use incentive spirometry. Chest radiography (CXR) and contrast-enhanced chest computed tomography (CT) demonstrated basilar airspace opacities involving the right lower and middle lobes. Repeat CBC showed that the Hb had dropped to 7.3 g/dL.
Question 1 : What is your provisional diagnosis and what are your next steps in management?
Answer 1: Acute chest syndrome complicating acute pain crisis; obtain stat blood cultures and initiate broad-spectrum empiric antibiotic therapy. A simple top-up blood transfusion of 1–2 units pRBC to Hb below 10 g/dL is recommended.
The patient defervesced and stabilized after initiation of antibiotic therapy, however, after 24 h, fever recurred with worsening hypoxia. Arterial blood gas demonstrated hypoxemia with an arterial oxygen partial pressure to fractional inspired oxygen ratio of 89 mm Hg. In the setting of worsening tachypnea with concern for impending respiratory failure, the patient was transferred to the ICU, endotracheal intubation was performed, and the patient was placed on mechanical ventilation. Total Hb was 7.9 g/dL with 48.6% HbS.
Question 2 : What is your next step in management?
Urgent exchange transfusion to reduce HbS fraction, continue intravenous hydration at maintenance rate and broad-spectrum empiric IV antibiotics.
Blood culture data remained negative. Her condition remarkably improved after 36 hours. She had an uneventful extubation and was safely discharged home after a total 13-day hospital stay.
ACS is often preceded by febrile episodes in children and by vaso-occlusive pain crisis in adults. Rapid recognition of ACS and prompt clinical intervention are necessary to prevent adverse health outcomes, especially in adults. Mainstays of treatment include judicious use of opioid analgesics to prevent respiratory compromise, supplemental oxygen therapy and arterial blood gas assessment, frequent use of bedside incentive spirometry in conjunction with respiratory therapy and empiric antibiotics, typically a cephalosporin and macrolide. Simple or exchange transfusion are indicated for the acute treatment of ACS; the decision to pursue exchange transfusion depends on the clinical severity and progression of ACS as well as the level of hemoglobin. If the patient is not on hydroxyurea (HU), initiate HU therapy at outpatient follow-up and encourage adherence to HU if the patient is on therapy to reduce/prevent future ACS episodes.
| Microorganism | Type of Infection | Comments |
|---|---|---|
| Streptococcus pneumoniae | Septicemia | Common despite prophylactic penicillin and pneumococcal vaccine |
| Meningitis | Less frequent than in years past | |
| Pneumonia | Rarely documented except in infants and young children | |
| Septic arthritis | Uncommon | |
| Haemophilus influenzae type b | Septicemia | |
| Meningitis | ||
| Pneumonia | Much less common in recent years because of immunization with conjugate vaccine | |
| Salmonella species | Osteomyelitis | |
| Septicemia | Most common cause of bone and joint infection | |
| Escherichia coli and other gram-negative enteric pathogens | Septicemia | |
| Urinary tract infection | ||
| Osteomyelitis | Focus sometimes not apparent | |
| Staphylococcus aureus | Osteomyelitis | Uncommon |
| Mycoplasma pneumoniae | Pneumonia | Pleural effusions; multilobe involvement |
| Chlamydia pneumoniae | Pneumonia | |
| Parvovirus B19 | Bone marrow suppression (aplastic crisis) | High fever common; rash and other organ involvement infrequent |
| Hepatitis viruses (A, B, and C) | Hepatitis | Marked hyperbilirubinemia |
As already noted, EPO deficiency from otherwise subclinical chronic renal damage may also contribute to a decline in Hb levels below baseline. The level of chronic anemia is a significant prognostic marker in SCD.
The treatment options for the chronic anemia of SCD have already been discussed earlier in this chapter.
Become a Clinical Tree membership for Full access and enjoy Unlimited articles
If you are a member. Log in here